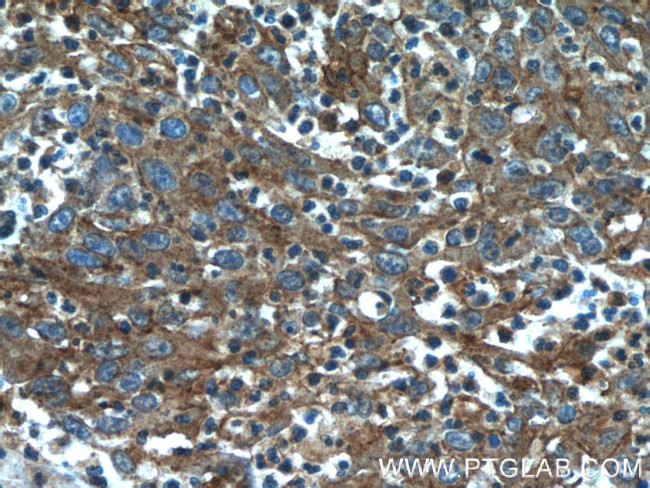
CYP1B1 Antibody in Immunohistochemistry (Paraffin) (IHC (P))

Search
Proteintech
CYP1B1 Polyclonal Antibody
{{$productOrderCtrl.translations['antibody.pdp.commerceCard.promotion.promotions']}}
{{$productOrderCtrl.translations['antibody.pdp.commerceCard.promotion.viewpromo']}}
{{$productOrderCtrl.translations['antibody.pdp.commerceCard.promotion.promocode']}}: {{promo.promoCode}} {{promo.promoTitle}} {{promo.promoDescription}}. {{$productOrderCtrl.translations['antibody.pdp.commerceCard.promotion.learnmore']}}
产品信息
18505-1-AP
种属反应
宿主/亚型
分类
类型
抗原
偶联物
形式
浓度
规格
纯化类型
保存液
内含物
保存条件
运输条件
产品详细信息
Immunogen sequence: MGTSLSPND PWPLNPLSIQ QTTLLLLLSV LATVHVGQRL LRQRRRQLRS APPGPFAWPL IGNAAAVGQA AHLSFARLAR RYGDVFQIRL GSCPIVVLNG ERAIHQALVQ QGSAFADRPA FASFRVVSGG RSMAFGHYSE HWKVQRRAAH SMMRNFFTRQ PRSRQVLEGH VLSEARELVA LLVRGSADGA FLDPRPLTVV AVANVMSAVC FGCRYSHDDP EFRELLSHNE EFGRTVGAGS LVDVMPWLQY FPNPVRTVFR (1-259 aa encoded by BC012049)
靶标信息
CYP1B1 is a 543 amino acid intracellular protein localized to the endoplasmic reticulum. It belongs to the cytochrome P450 super family of enzymes which are monooxygenases and it catalyzes many reactions involved in drug metabolism and synthesis of cholesterol, steroids and other lipids. This enzyme metabolizes procarcinogens such as polycyclic aromatic hydrocarbons and 17beta-estradiol and is also involved in the metabolism of substances active in the eye growth and differentiation and hence plays a putative role in ocular development. Mutated proteins are known to cause primary congenital glaucoma.
仅用于科研。不用于诊断过程。未经明确授权不得转售。
生物信息学
蛋白别名: aryl hydrocarbon hydroxylase; benz[a]anthracene inducible; CYPIB1; Cytochrome P450 1B1; cytochrome P450, 1b1, benz[a]anthracene inducible; cytochrome P450, family 1, subfamily B, polypeptide 1; cytochrome P450, subfamily 1B, polypeptide 1; cytochrome P450, subfamily I (dioxin-inducible), polypeptide 1 (glaucoma 3, primary infantile); Cytochrome P450CMEF; Cytochrome P450EF; Cytochrome P450RAP; dioxin-inducible cytochrome p450; flavoprotein-linked monooxygenase; Hydroperoxy icosatetraenoate dehydratase; microsomal monooxygenase; P450RAP; unnamed protein product; xenobiotic monooxygenase
基因别名: ASGD6; CP1B; Cyp1-b1; CYP1B1; CYPIB1; GLC3A; P4501B1
UniProt ID: (Human) Q16678, (Rat) Q64678, (Mouse) Q64429
Entrez Gene ID: (Human) 1545, (Rat) 25426, (Mouse) 13078